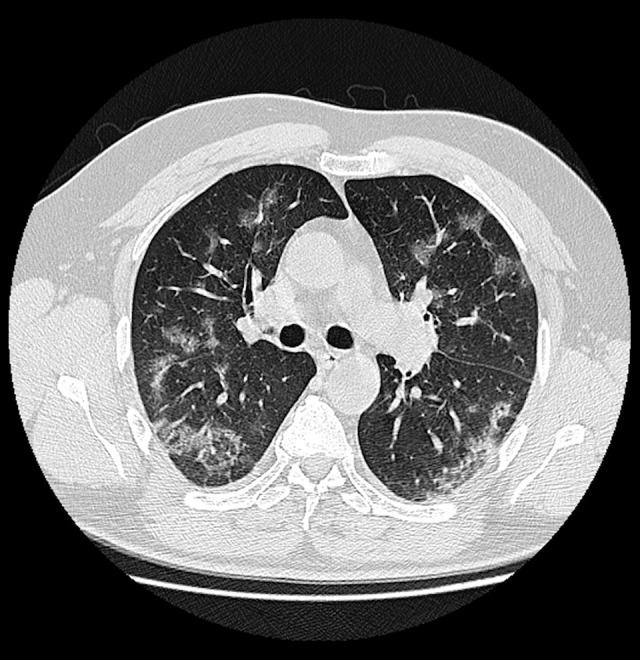
https://cdn.ncbi.nlm.nih.gov/pmc/blobs/1eb3/8186270/6e7bb5fd7516/medscimonit-27-e931285-g002.jpg

胸部计算机断层扫描 (CT) 预测冠状病毒病的临床病程。
Chest Computed Tomography (CT) as a Predictor of Clinical Course in Coronavirus Disease.
机构信息
Department of Radiology, Centre for Postgraduate Medical Education, Warsaw, Poland.
Diagnostic Radiology Department, Central Clinical Hospital of the Ministry of the Interior in Warsaw, Warsaw, Poland.
出版信息
Med Sci Monit. 2021 Jun 3;27:e931285. doi: 10.12659/MSM.931285.
BACKGROUND Chest imaging may be taken into consideration in detecting viral lung infections, especially if there are no tests available or there is a need for a prompt diagnosis. Imaging modalities enable evaluation of the character and extent of pulmonary lesions and monitoring of the disease course. The aim of this study was to verify the prognostic value of chest CT in COVID-19 patients. MATERIAL AND METHODS We conducted a retrospective review of clinical data and CT scans of 156 patients with SARS-CoV-2 infection confirmed by real-time reverse-transcription polymerase-chain-reaction (rRT-PCR) assay hospitalized in the Central Clinical Hospital of the Ministry of the Interior in Warsaw and in the Medical Centre in Łańcut, Poland. The total severity score (TSS) was used to quantify the extent of lung opacification in CT scans. RESULTS The dominant pattern in discharged patients was ground-glass opacities, whereas in the non-survivors, the dominant pulmonary changes were consolidations. The non-survivors were more likely to have pleural effusion, pleural thickening, lymphadenopathy, air bronchogram, and bronchiolectasis. There were no statistically significant differences among the 3 analyzed groups (non-survivors, discharged patients, and patients who underwent prolonged hospitalization) in the presence of fibrotic lesions, segmental or subsegmental pulmonary vessel enlargement, subpleural lines, air bubble sign, and halo sign. CONCLUSIONS Lung CT is a diagnostic tool with prognostic utility in COVID-19 patients. The correlation of the available clinical data with semi-quantitative radiological features enables evaluation of disease severity. The occurrence of specific radiomics shows a positive correlation with prognosis.
背景
胸部影像学检查可用于检测病毒性肺部感染,尤其是在无法进行检测或需要快速诊断的情况下。影像学检查可评估肺部病变的性质和范围,并监测疾病进程。本研究旨在验证胸部 CT 在 COVID-19 患者中的预后价值。
材料与方法
我们对 156 例经实时逆转录聚合酶链反应(rRT-PCR)检测证实为 SARS-CoV-2 感染的患者的临床数据和 CT 扫描进行了回顾性分析,这些患者均住院于波兰华沙内政部中央临床医院和波兰拉奇努特医疗中心。总严重程度评分(TSS)用于量化 CT 扫描中肺混浊的程度。
结果
出院患者的主要表现为磨玻璃影,而未存活患者的主要肺部改变为实变。未存活患者更有可能出现胸腔积液、胸膜增厚、淋巴结病、空气支气管征和支气管扩张。在 3 个分析组(未存活患者、出院患者和住院时间延长的患者)中,纤维化病变、肺段或亚段血管扩大、胸膜下线、气液征和晕征的存在无统计学差异。
结论
肺部 CT 是 COVID-19 患者具有预后价值的诊断工具。将现有临床数据与半定量影像学特征相结合,可评估疾病严重程度。特定放射组学特征的出现与预后呈正相关。